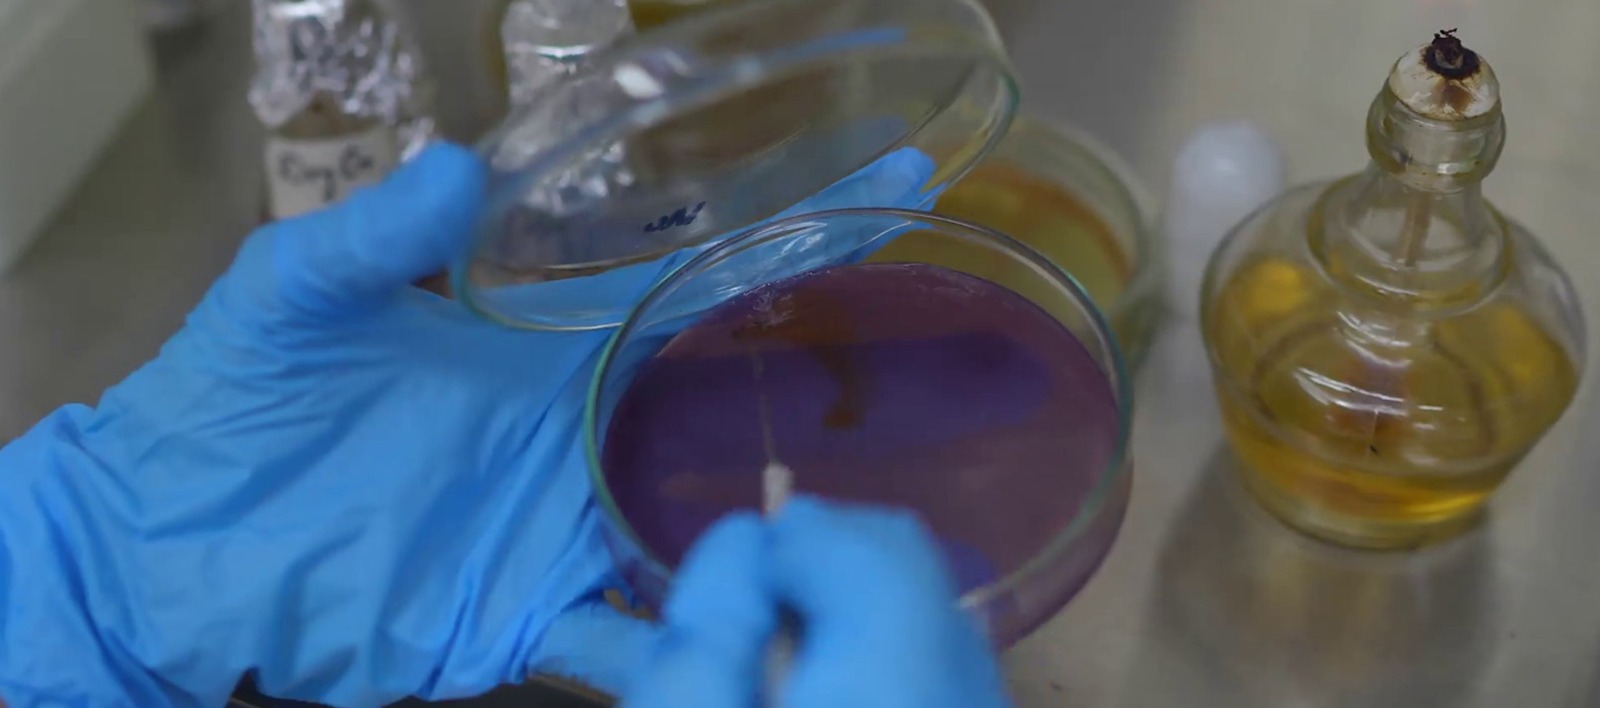
WhatsApp Image 2025-12-30 at 17.09.23_322e8991

Instrumentation

Facilities
Advanced Laboratory Infrastructure
Our laboratory features purpose-built facilities designed to meet national and international forensic standards.
Our sections are managed by trained forensic scientists and operate under strict quality assurance protocols.

Advance Lab infrastructure

Modern Equipment

Digital Records

